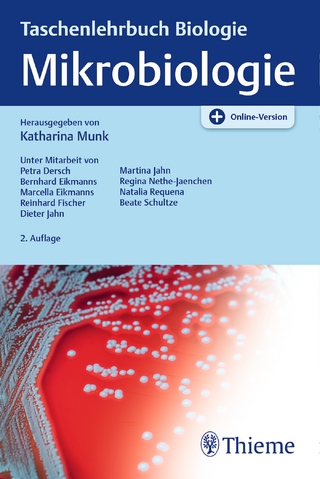
Mikrobiologie

eBook Download (EPUB)
2018
|
Auflage:
9
|
Thieme
ISBN: 9783132410329
44,99 €
(CHF 43,95) (inkl. MwSt)
(CHF 43,95) (inkl. MwSt)
- Download sofort lieferbar